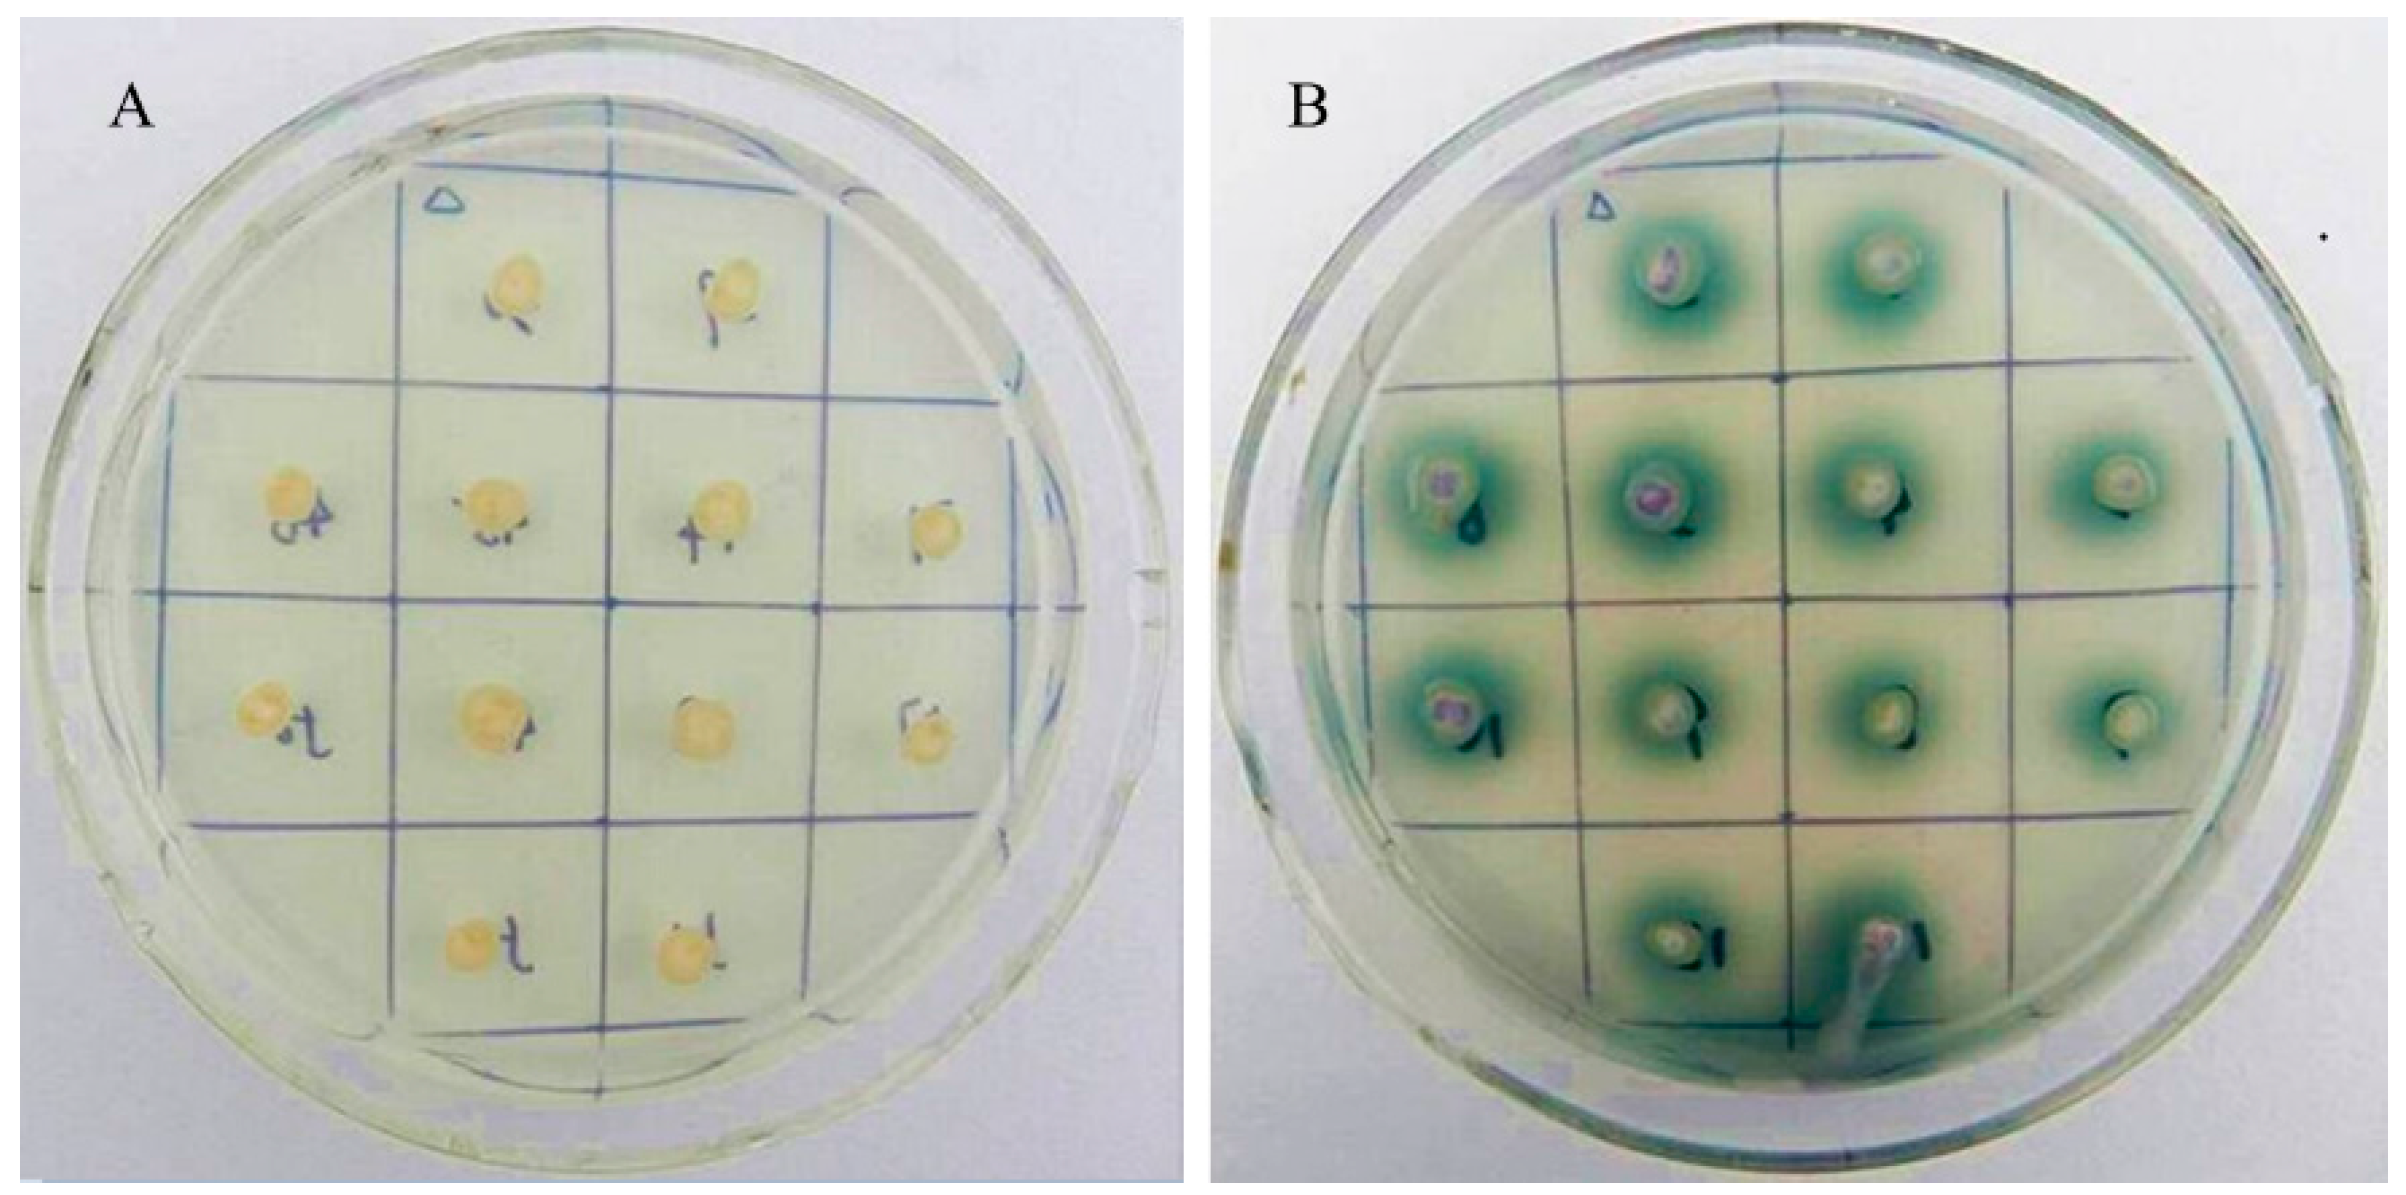

Cloning and Expression Analysis of Vvlcc3, a Novel and Functional Laccase Gene Possibly Involved in Stipe Elongation
Abstract
:1. Introduction
2. Results
2.1. Laccase Genes in the V. volvacea Genome and Their Transcription Patterns

| Vvlcc 1 | Vvlcc 2 | Vvlcc 3 | Vvlcc 4 | Vvlcc 5 | Vvlcc 6 | Vvlcc 7 | Vvlcc 8 | Vvlcc 9 | Vvlcc 10 | Vvlcc 11 | |
|---|---|---|---|---|---|---|---|---|---|---|---|
| BU | 0 | 1.96 | 8.73 | 4.99 | 0.36 | 0 | 0 | 0 | 0.18 | 0 | 0.89 |
| EG | 0.33 | 0.33 | 71.09 | 14.55 | 3.34 | 0.50 | 0 | 0 | 1.50 | 0 | 1.34 |
| EL | 0 | 0 | 92.20 | 9.88 | 0 | 0.67 | 0 | 0 | 1.17 | 0 | 0.50 |
| MA | 0 | 1.17 | 27.14 | 11.23 | 0 | 1.01 | 0 | 0 | 0.50 | 0 | 0 |

2.2. The Structure of Vvlcc3 Gene

2.3. Characterization of VvLCC3 Protein and Phylogenetic Tree


2.4. Heterologous Expression of Vvlcc3 in P. pastoris

3. Discussion
4. Experimental Section
4.1. Strains and Vectors
4.2. Isolation of Total RNA
4.3. Transcription Pattern Analysis of Laccase Genes in V. volvacea with DGE Data
4.4. Cloning of Vvlcc3 cDNA, Construction of Expression Vector and Transformation
4.5. Expression, Purification and Analysis of Heterologous VvLCC3
4.6. Protein Sequences Analysis and Phylogenetic Tree Construction
Supplementary Materials
Acknowledgments
Author Contributions
Conflicts of Interest
References
- Tao, Y.; Xie, B.; Yang, Z.; Chen, Z.; Chen, B.; Deng, Y.; Jiang, Y.; van Peer, A.F. Identification and expression analysis of a new glycoside hydrolase family 55 exo-β-1, 3-glucanase-encoding gene in Volvariella volvacea suggests a role in fruiting body development. Gene 2013, 527, 154–160. [Google Scholar] [CrossRef] [PubMed]
- Chang, S.T.; Yau, C.K. Volvariella volvacea and its Life History. Am. J. Bot. 1971, 58, 552–561. [Google Scholar] [CrossRef]
- Mau, J.L.; Chyau, C.C.; Li, J.Y.; Tseng, Y.H. Flavor compounds in straw mushrooms Volvariella volvacea harvested at different stages of maturity. J. Agric. Food Chem. 1997, 45, 4726–4729. [Google Scholar] [CrossRef]
- Ahlawat, O.P.; Mohapatra, K.B.; Kaur, H.; Singh, M. Genetic variability in strains of Volvariella volvacea collected from the state of Odisha, India. In Proceedings of the 8th International Conference on Mushroom Biology and Mushroom Products (ICMBMP8), New Delhi, India, 19–22 November 2014.
- Montgomery, G.W.G.; Adams, D.; Gooday, G. Studies on the purification of chitin synthase from Coprinus cinereus. J. Gen. Microbiol. 1984, 130, 291–297. [Google Scholar] [CrossRef]
- Shioya, T.; Nakamura, H.; Ishii, N.; Takahashi, N.; Sakamoto, Y.; Ozaki, N.; Kobayashi, M.; Okano, K.; Kamada, T.; Muraguchi, H. The Coprinopsis cinerea septin Cc.Cdc3 is involved in stipe cell elongation. Fungal Genet. Biol. 2013, 58–59, 80–90. [Google Scholar] [CrossRef] [PubMed]
- Muraguchi, H.; Kamada, T. A mutation in the eln2 gene encoding a cytochrome P450 of Coprinus cinereus affects mushroom morphogenesis. Fungal Genet. Biol. 2000, 29, 49–59. [Google Scholar] [CrossRef] [PubMed]
- Wang, W.; Liu, F.; Jiang, Y.; Wu, G.; Guo, L.; Chen, R.; Chen, B.; Lu, Y.; Dai, Y.; Xie, B. The multigene family of fungal laccases and their expression in the white rot basidiomycete Flammulina velutipes. Gene 2015, 563, 142–149. [Google Scholar] [CrossRef] [PubMed]
- Giardina, P.; Faraco, V.; Pezzella, C.; Piscitelli, A.; Vanhulle, S.; Sannia, G. Laccases: A never-ending story. Cell. Mol. Life Sci. 2010, 67, 369–385. [Google Scholar] [CrossRef] [PubMed]
- Perry, C.R.; Matcham, S.E.; Wood, D.A.; Thurston, C.F. The structure of laccase protein and its synthesis by the commercial mushroom Agaricus bisporus. Microbiology 1993, 139, 171–178. [Google Scholar] [CrossRef] [PubMed][Green Version]
- Alves, A.M.C.R.; Record, E.; Lomascolo, A.; Scholtmeijer, K.; Asther, M.; Wessels, J.G.H.; Wösten, H.A.B. Highly efficient production of laccase by the basidiomycete Pycnoporus cinnabarinus. Appl. Environ. Microbiol. 2004, 70, 6379–6384. [Google Scholar] [CrossRef] [PubMed]
- Necochea, R.; Valderrama, B.; Díaz-Sandoval, S.; Folch-Mallol, J.L.; Vázquez-Duhalt, R.; Iturriaga, G. Phylogenetic and biochemical characterization of a recombinant laccase from Trametes versicolor. FEMS Microbiol. Lett. 2005, 244, 235–241. [Google Scholar] [CrossRef] [PubMed]
- Kilaru, S.; Hoegger, P.J.; Kües, U. The laccase multi-gene family in Coprinopsis cinerea has seventeen different members that divide into two distinct subfamilies. Curr. Genet. 2006, 50, 45–60. [Google Scholar] [CrossRef] [PubMed]
- Bleve, G.; Lezzi, C.; Mita, G.; Rampino, P.; Perrotta, C.; Villanova, L.; Grieco, F. Molecular cloning and heterologous expression of a laccase gene from Pleurotus eryngii in free and immobilized Saccharomyces cerevisiaecells. Appl. Microbiol. Biotechnol. 2008, 79, 731–741. [Google Scholar] [CrossRef] [PubMed]
- Courty, P.E.; Hoegger, P.J.; Kilaru, S.; Kohler, A.; Buée, M.; Garbaye, J.; Martin, F.; Kües, U. Phylogenetic analysis, genomic organization, and expression analysis of multi-copper oxidases in the ectomycorrhizal basidiomycete Laccaria bicolor. New Phytol. 2009, 182, 736–750. [Google Scholar] [CrossRef] [PubMed]
- Lettera, V.; Piscitelli, A.; Leo, G.; Birolo, L.; Pezzella, C.; Sannia, G. Identification of a new member of Pleurotus ostreatus laccase family from mature fruiting body. Fungal Biol. 2010, 114, 724–730. [Google Scholar] [CrossRef] [PubMed]
- Tsai, H.F.; Wheeler, M.H.; Chang, Y.C.; Kwon-Chung, K.J. A developmentally regulated gene cluster involved in conidial pigment biosynthesis in Aspergillus fumigatus. J. Bacteriol. 1999, 181, 6469–6477. [Google Scholar] [PubMed]
- Chen, S.; Ge, W.; Buswell, J.A. Molecular cloning of a new laccase from the edible straw mushroom Volvariella volvacea: Possible involvement in fruit body development. FEMS Microbiol. Lett. 2004, 230, 171–176. [Google Scholar] [CrossRef]
- Leonowicz, A.; Cho, N.-S.; Luterek, J.; Wilkolazka, A.; Wojtas-Wasilewska, M.; Matuszewska, A.; Hofrichter, M.; Wesenberg, D.; Rogalski, J. Fungal laccase: Properties and activity on lignin. J. Basic Microbiol. 2001, 41, 185–227. [Google Scholar] [CrossRef]
- Kües, U.; Rühl, M. Multiple multi-copper oxidase gene families in basidiomycetes-What for? Curr. Genom. 2011, 12, 72–94. [Google Scholar] [CrossRef] [PubMed]
- Chen, S.; Ge, W.; Buswell, J.A. Biochemical and molecular characterization of a laccase from the edible straw mushroom, Volvariella volvacea. Eur. J. Biochem. 2004, 271, 318–328. [Google Scholar] [CrossRef] [PubMed]
- Bao, D.; Gong, M.; Zheng, H.; Chen, M.; Zhang, L.; Wang, H.; Jiang, J.; Wu, L.; Zhu, Y.; Zhu, G.; et al. Sequencing and Comparative Analysis of the Straw Mushroom (Volvariella volvacea) Genome. PLoS ONE 2013, 8, e58294. [Google Scholar] [CrossRef] [PubMed]
- C.’t Hoen, P.A.; Ariyurek, Y.; Thygesen, H.H.; Vreugdenhil, E.; Vossen, R.H.; de Menezes, R.X.; Boer, J.M.; van Ommen, G.J.; den Dunnen, J.T. Deep sequencing-based expression analysis shows major advances in robustness, resolution and inter-lab portability over five microarray platforms. Nucleic Acids Res. 2008, 36, e141. [Google Scholar] [CrossRef] [PubMed]
- Gurr, S.J.; Unkles, S.E.; Kinghorn, J.R. The structure and organization of nuclear genes of filamentous fungi. Spec. Publ. Soc. Gen. Microbiol. 1987, 22, 93–139. [Google Scholar]
- Ahlawat, O.P.; Billette, C. Positioning of introns in different laccase genes, a relevant tool for solving phylogenetic positionambiguity of Volvariellavolvacea laccase genes. In Proceedings of the 7th International Conference on Mushroom Biology and Mushroom Products (ICMBMP7), Arcachon, France, 4–7 October 2011; Savoie, J.M., Foulongne-Oriol, M., Largeteau, M., Barroso, G., Eds.; Volume 7, pp. 100–112.
- Hoegger, P.J.; Kilaru, S.; James, T.Y.; Thacker, J.R.; Kües, U. Phylogenetic comparison and classification of laccase and related multicopper oxidase protein sequences. FEBS J. 2006, 273, 2308–2326. [Google Scholar] [CrossRef] [PubMed]
- Thurston, C.F. The structure and function of fungal laccases. Microbiology 1994, 140, 19–26. [Google Scholar] [CrossRef]
- Bao, W.; O’Malley, D.M.; Whetten, R.; Sederoff, R.R. A laccase associated with lignification in loblolly pine xylem. Science 1993, 260, 672–674. [Google Scholar] [CrossRef] [PubMed]
- De Marco, A.; Roubelakis-Angelakis, K.A. Laccase activity could contribute to cell-wall reconstitution in regenerated protoplasts. Phytochemistry 1997, 46, 421–425. [Google Scholar] [CrossRef]
- Aramayo, R.; Timberlake, W.E. Sequence and molecular structure of the Aspergillus nidulans yA (laccase I) gene. Nucleic Acids Res. 1990, 18, 3415. [Google Scholar] [CrossRef] [PubMed]
- Eggert, C.; LaFayette, P.R.; Temp, U.; Eriksson, K.E.; Dean, J.F. Molecular analysis of a laccase gene from the white-rot fungus Pycnoporus cinnabarinus. Appl. Environ. Microbiol. 1998, 64, 1766–1772. [Google Scholar] [PubMed]
- Germann, U.A.; Muller, G.; Hunziker, P.E.; Lerch, K. Characterization of two allelic forms of Neurospora crassa laccase. Amino- and carboxyl-terminal processing of a precursor. J. Biol. Chem. 1998, 263, 885–896. [Google Scholar]
- Hatakka, A. Lignin-modifying enzymes from selected white-rot fungi, production and role in lignin degradation. FEMS Microbiol. Rev. 1994, 13, 125–135. [Google Scholar] [CrossRef]
- Alexandre, G.; Zhulin, I.B. Laccases are widespread in bacteria. Trends Biotechnol. 2000, 18, 41–42. [Google Scholar] [CrossRef]
- Diamantidis, G.; Effosse, A.; Potier, P.; Bally, R. Purification and characterization of the first bacterial laccase in the rhizospheric bacterium Azospirillum lipoferum. Soil Biol. Biochem. 2000, 32, 919–927. [Google Scholar] [CrossRef]
- Hullo, M.F.; Moszer, I.; Danchin, A.; Martin-Verstraete, I. CotA of Bacillus subtilis is a copper-dependent laccase. J. Bacteriol. 2001, 183, 5426–5430. [Google Scholar] [CrossRef] [PubMed]
- Sanchez-Amat, A.; Lucas-Elio, P.; Fernández, E.; Garcı́a-Borrón, J.C.; Solano, F. Molecular cloning and functional characterization of a unique multipotent polyphenol oxidase from Marinomonas mediterranea. Biochim. Biophys. Acta (BBA)-Protein Struct. Mol. Enzymol. 2001, 1547, 104–116. [Google Scholar] [CrossRef]
- Sharma, P.; Goel, R.; Capalash, N. Bacterial laccases. World J. Microbiol. Biotechnol. 2007, 23, 823–832. [Google Scholar] [CrossRef]
- Parkinson, N.M.; Conyers, C.M.; Keen, J.N.; MacNicoll, A.D.; Smith, I.; Weaver, R.J. cDNAs encoding large venom proteins from the parasitoid wasp Pimpla hypochondriaca identified by random sequence analysis. Comp. Biochem. Physiol. Part C Toxicol. Pharmacol. 2003, 134, 513–520. [Google Scholar] [CrossRef]
- Sato, Y.; Wuli, B.; Sederoff, R.; Whetten, R. Molecular cloning and expression of eight laccase cDNAs in loblolly pine (Pinus taeda). J. Plant Res. 2001, 114, 147–155. [Google Scholar] [CrossRef]
- Kumar, S.V.; Phale, P.S.; Durani, S.; Wangikar, P.P. Combined sequence and structure analysis of the fungal laccase family. Biotechnol. Bioeng. 2003, 83, 386–394. [Google Scholar] [CrossRef] [PubMed]
- Cai, Y.J.; Buswell, J.A.; Chang, S.T. Production of cellulases and hemicellulases by the straw mushroom, Volvariella volvacea. Mycol. Res. 1994, 98, 1019–1024. [Google Scholar] [CrossRef]
- Bu’lock, J.D. Fungal metabolites with structural function. In Essays in Biosynthesis and Microbial Development: E.R. Squibb Lectures on Chemistry of Microbial Products; John Wiley: New York, NY, USA, 1967; pp. 1–18. [Google Scholar]
- Tao, Y.; van Peer, A.F.; Chen, B.; Chen, Z.; Zhu, J.; Deng, Y.; Jiang, Y.; Li, S.; Wu, T.; Xie, B. Gene Expression Profiling Reveals Large Regulatory Switches between Succeeding Stipe Stages in Volvariella volvacea. PLoS ONE 2014, 9, e97789. [Google Scholar] [CrossRef] [PubMed]
- Livak, K.J.; Schmittgen, T.D. Analysis of relative gene expression data using real-time quantitative PCR and the 2−ΔΔCt method. Methods 2001, 25, 402–408. [Google Scholar] [CrossRef] [PubMed]
- Fan, F.; Zhuo, R.; Sun, S.; Wan, X.; Jiang, M.; Zhang, X.; Yang, Y. Cloning and functional analysis of a new laccase gene from Trametes sp.48424 which had the high yield of laccase and strong ability for decolorizing different dyes. Bioresour. Technol. 2011, 102, 3126–3137. [Google Scholar] [CrossRef] [PubMed]
- Chen, S.; Ma, D.; Ge, W.; Buswell, J.A. Induction of laccase activity in the edible straw mushroom, Volvariella volvacea. FEMS Microbiol. Lett. 2003, 218, 143–148. [Google Scholar] [CrossRef] [PubMed]
- Bao, S.; Teng, Z.; Ding, S. Heterologous expression and characterization of a novel laccase isoenzyme with dyes decolorization potential from Coprinus comatus. Mol. Boil. Rep. 2013, 40, 1927–1936. [Google Scholar] [CrossRef] [PubMed]
- Gasteiger, E.; Hoogland, C.; Gattiker, A.; Duvaud, S.; Wilkins, M.R.; Appel, R.D.; Bairoch, A. Protein identification and analysis tools on the ExPASy server. In the Proteomics Protocols Handbook; John, M.W., Ed.; Humana Press Inc.: Totowa, NJ, USA, 2005; pp. 571–607. [Google Scholar]
- Petersen, T.N.; Brunak, S.; von Heijne, G.; Nielsen, H. SignalP 4.0: Discriminating signal peptides from transmembrane regions. Nat. Methods 2011, 8, 785–786. [Google Scholar] [CrossRef] [PubMed]
- Quevillon, E.; Silventoinen, V.; Pillai, S.; Harte, N.; Mulder, N.; Apweiler, R.; Lopez, R. InterProScan: Protein domains identifier. Nucleic Acids Res. 2005, 33, 116–120. [Google Scholar] [CrossRef] [PubMed]
- Pezzella, C.; Autore, F.; Giardina, P.; Piscitelli, A.; Sannia, G.; Faraco, V. The Pleurotus ostreatus laccase multi-gene family members. Curr. Genet. 2009, 55, 45–57. [Google Scholar] [CrossRef] [PubMed]
- Valderrama, B.; Oliver, P.; Medrano-Soto, A.; Vazquez-Duhalt, R. Evolutionary and structural diversity of fungal laccases. Antonie van Leeuwenhoek 2003, 84, 289–299. [Google Scholar] [CrossRef] [PubMed]
- Thompson, J.D.; Gibson, T.J.; Plewniak, F.; Jeanmougin, F.; Higgins, D.G. The clustal_x windows interface: flexible strategies for multiple sequence alignment aided by quality analysis tools. Nuleic Acids Res. 1997, 25, 4876–4882. [Google Scholar] [CrossRef]
- Dereeper, A.; Guignon, V.; Blanc, G.; Audic, S.; Buffet, S.; Chevenet, F.; Dufayard, J.F.; Guindon, S.; Lefort, V.; Lescot, M.; et al. Phylogeny.fr: Robust phylogenetic analysis for the non-specialist. Nucleic Acids Res. 2008, 36, 465. [Google Scholar] [CrossRef] [PubMed]
- Edgar, R.C. MUSCLE: Multiple sequence alignment with high accuracy and high throughput. Nucleic Acids Res. 2004, 19, 1792–1797. [Google Scholar] [CrossRef] [PubMed]
- Castresana, J. Selection of conserved blocks from multiple alignments for their use in phylogenetic analysis. Mol. Biol. Evol. 2000, 17, 540–552. [Google Scholar] [CrossRef] [PubMed]
- Guindon, S.; Dufayard, J.F.; Lefort, V.; Anisimova, M.; Hordijk, W.; Gascuel, O. New Algorithms and Methods to Estimate Maximum-Likelihood Phylogenies: Assessing the Performance of PhyML 3.0. Syst. Biol. 2010, 59, 307–321. [Google Scholar] [CrossRef] [PubMed]
© 2015 by the authors; licensee MDPI, Basel, Switzerland. This article is an open access article distributed under the terms and conditions of the Creative Commons by Attribution (CC-BY) license (http://creativecommons.org/licenses/by/4.0/).
Share and Cite
Lu, Y.; Wu, G.; Lian, L.; Guo, L.; Wang, W.; Yang, Z.; Miao, J.; Chen, B.; Xie, B. Cloning and Expression Analysis of Vvlcc3, a Novel and Functional Laccase Gene Possibly Involved in Stipe Elongation. Int. J. Mol. Sci. 2015, 16, 28498-28509. https://doi.org/10.3390/ijms161226111
Lu Y, Wu G, Lian L, Guo L, Wang W, Yang Z, Miao J, Chen B, Xie B. Cloning and Expression Analysis of Vvlcc3, a Novel and Functional Laccase Gene Possibly Involved in Stipe Elongation. International Journal of Molecular Sciences. 2015; 16(12):28498-28509. https://doi.org/10.3390/ijms161226111
Chicago/Turabian StyleLu, Yuanping, Guangmei Wu, Lingdan Lian, Lixian Guo, Wei Wang, Zhiyun Yang, Juan Miao, Bingzhi Chen, and Baogui Xie. 2015. "Cloning and Expression Analysis of Vvlcc3, a Novel and Functional Laccase Gene Possibly Involved in Stipe Elongation" International Journal of Molecular Sciences 16, no. 12: 28498-28509. https://doi.org/10.3390/ijms161226111
APA StyleLu, Y., Wu, G., Lian, L., Guo, L., Wang, W., Yang, Z., Miao, J., Chen, B., & Xie, B. (2015). Cloning and Expression Analysis of Vvlcc3, a Novel and Functional Laccase Gene Possibly Involved in Stipe Elongation. International Journal of Molecular Sciences, 16(12), 28498-28509. https://doi.org/10.3390/ijms161226111
